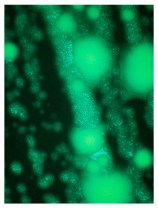
Cover_01 1

Cell Host and Microbe has published Bollyky lab research in the 2015 November issue. Click here to read the full article or read the summary below.
Biofilms—communities of bacteria encased in a polymer-rich matrix—confer bacteria with the ability to persist in pathologic host contexts, such as the cystic fibrosis (CF) airways. How bacteria assemble polymers into biofilms is largely unknown. We find that the extracellular matrix produced by Pseudomonas aeruginosa self-assembles into a l iquid crystal through entropic interactions between polymers and filamentous Pf bacteriophages, which are long, negatively charged filaments (see video clip below). This liquid crystalline structure enhances biofilm function by increasing adhesion and tolerance to desiccation and antibiotics. Pf bacteriophages are prevalent among P. aeruginosa clinical isolates and were detected in CF sputum. The addition of Pf bacteriophage to sputum polymers or serum was sufficient to drive their rapid assembly into viscous liquid crystals. Fd, a related bacteriophage of Escherichia coli, has similar biofilm-building capabilities. Targeting filamentous bacteriophage or the liquid crystalline organization of the biofilm matrix may represent antibacterial strategies.
iquid crystal through entropic interactions between polymers and filamentous Pf bacteriophages, which are long, negatively charged filaments (see video clip below). This liquid crystalline structure enhances biofilm function by increasing adhesion and tolerance to desiccation and antibiotics. Pf bacteriophages are prevalent among P. aeruginosa clinical isolates and were detected in CF sputum. The addition of Pf bacteriophage to sputum polymers or serum was sufficient to drive their rapid assembly into viscous liquid crystals. Fd, a related bacteriophage of Escherichia coli, has similar biofilm-building capabilities. Targeting filamentous bacteriophage or the liquid crystalline organization of the biofilm matrix may represent antibacterial strategies.